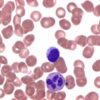

| Tên sản phẩm: | IBX polystyrene Novabiochem® |
| Code: | 8550430025 |
| Hãng – Xuất xứ: | Merck – Đức |
| Ứng dụng: |
– Hóa chất được sử dụng làm khối xây dựng dùng trong tổng hợp peptid pha rắn trong các phòng thí nghiệm, viện nghiên cứu,… |
| Tính chất: |
– Dạng: rắn – Màu sắc: màu trắng |
| Bảo quản: | Lưu trữ từ 2°C đến 8°C |
| Quy cách: | Chai nhựa 25g |
Sản phẩm tham khảo:
| Code | Quy cách |
| 8550430001 | Chai thủy tinh 1g |
| 8550430005 | Chai thủy tinh 5g |
| 8550430025 | Chai nhựa 25g |

Đánh giá
Chưa có đánh giá nào.